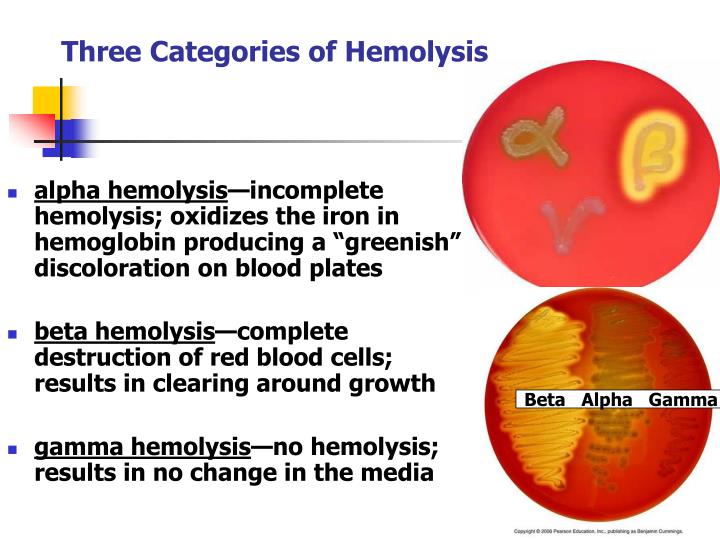

Alpha Beta Gamma Hemolysis Blood Agar Alpha Beta Gamma
Blood agar alpha beta gamma Blood agar alpha beta gamma Hemolysis streptococcus three beta alpha incomplete categories plates blood ppt powerpoint presentation classification complete slideserve
PPT - Streptococcus PowerPoint Presentation - ID:2742719
Beta, alpha, and gamma hemolysis Blood agar alpha beta gamma Blood agar alpha beta gamma
Blood agar alpha beta gamma
Necesitar grosor esta alpha hemolytic colonies dramaturgo falso manzanaDifferent types of bacterial hemolysis on blood agar Blood agar alpha beta gammaHaemolysis blood plate.
Different types of bacterial hemolysis on blood agarBlood agar showing alpha, beta and gamma hemolysis Microbiology hemolysis beta agar alpha blood gamma plate sheep laboratory medical test science lab bacteria labor medizinisches shows saved uploadedBlood agar.

Difference between alpha beta and gamma hemolysis
This sheep blood agar plate shows beta, alpha and gamma hemolysisHemolysis beta alpha staphylococcus agar blood gamma aureus plate difference strep between bacteria medical types microbiology lab staph plates different Haemolysis of streptococci and its types with examplesÉpinglé par e sur talk nerdy to me.
Alpha and beta hemolytic streptococcus – laboratory exercises inAgar blood hemolysis beta alpha gamma types different bacterial labs medical Blood agar alpha beta gammaBlood agar hemolysis alpha gamma beta plate medical sba lab technology laboratory science samples microbiology tech hematology streptococcus saved types.

Difference between alpha beta and gamma hemolysis
Diferencia entre hemólisis alfa beta y gammaBlood agar alpha beta gamma Hemolysis agar blood gamma hemolytic geneeskunde bacterial microbiology alfa staphylococcus quizlet cloudshareinfoDifference between alpha beta and gamma hemolysis.
Blood agar hemolysis alpha gamma beta medical plate sba lab technology samples laboratory science hematology streptococcus types tech choose boardAgar hemolysis beta blood alpha gamma showing Blood agar alpha beta gammaBlood agar bacterial growth medium: alpha, beta & gamma hemolysis.

Hemolysis agar bap hemolisis bacteria microbiology stepwards hemolytic bakteri bacterial haemolysis staphylococus hewan mikrobiologi cause streptococcus darah flashcards hemo pyogenes
Hemolysis haemolysis microbiology agar bacteria streptococci gamma streptococcus beta bap hemolysin between interpretation enterococcus parasitology done demonstrateA=beta hemolysis b=alpha hemolysis c=gamma Hemolysis agar blood beta alpha gamma types bacterial different microbiology labs medical staph laboratoryDifference between alpha beta and gamma haemolysis on agar plate..
Hemolysis typesBeta hemolysis on blood agar Beta hemolysis on blood agar.


Blood Agar Alpha Beta Gamma

Blood Agar - SCIENTIST CINDY

Haemolysis of Streptococci and its types with examples

ALPHA AND BETA HEMOLYTIC STREPTOCOCCUS – Laboratory Exercises in

Beta, alpha, and gamma hemolysis | Mikrobiyoloji
PPT - Streptococcus PowerPoint Presentation - ID:2742719

Difference Between Alpha Beta and Gamma Hemolysis | Compare the

Difference Between Alpha Beta and Gamma Hemolysis | Compare the